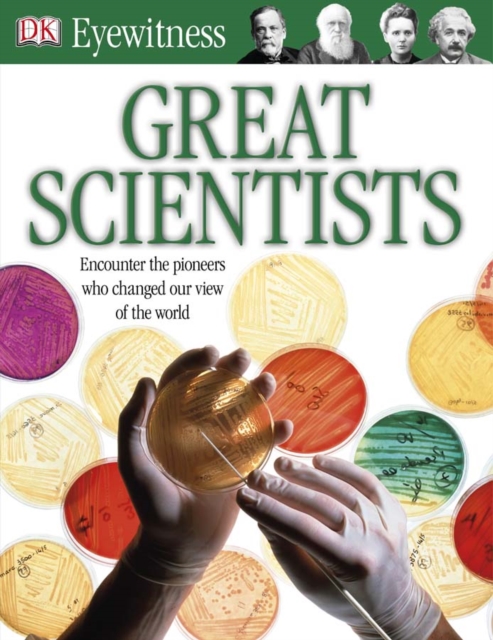
Great Scientists

Great Scientists
DK Eyewitness Great Scientists is an exciting and informative guide to the fascinating lives of the world''s most famous thinkers, philosophers, inventors, innovators and pioneers. Stunning photographs offer a unique "eyewitness" view of the ideas and innovations that have changed the way we live today.
Your child will discover all about Benjamin Franklin''s electrical charges, Albert Einstein''s t...
DK Eyewitness Great Scientists is an exciting and informative guide to the fascinating lives of the world''s most famous thinkers, philosophers, inventors, innovators and pioneers. Stunning photographs offer a unique "eyewitness" view of the ideas and innovations that have changed the way we live today.
Your child will discover all about Benjamin Franklin''s electrical charges, Albert Einstein''s t...
